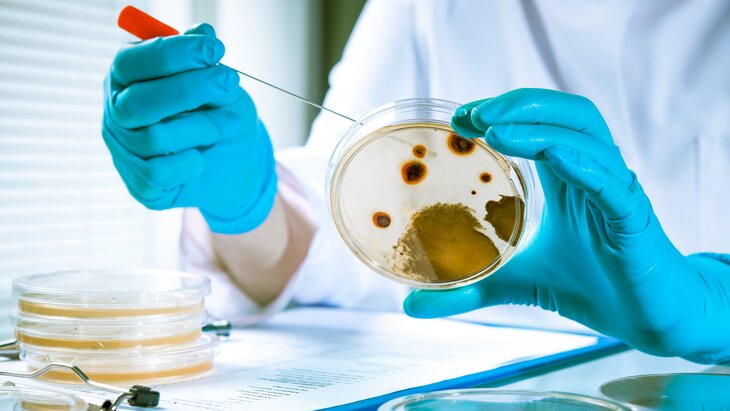

07 сентября 2023, 11:23
ОбществоБританские ученые опровергли мифы о микробах, живущих в кишечнике
Фото: depositphotos/alexraths
Британские ученые опровергли мифы о микробах, живущих в кишечнике, сообщает РИА Новости.
"В каждом из нас обитают десятки триллионов микроорганизмов. Некоторые выполняют очень важные функции – участвуют в метаболических и иммунных процессах. Роль других пока не выяснили", – отмечается в сообщении.
Новые данные об этом ученые получают регулярно. Они не всегда соотносятся с общепринятыми представлениями.
Первый миф, который развенчали британские ученые, – о микрофлоре. Часто этим термином называют совокупность микроорганизмов в теле человека, однако флора – это растения. Сообщество бактерий, архей, грибов, вирусов и простейших организмов, которые существуют в симбиозе с человеком, называется микробиотой или микробиомом.
Эти составляющие населяют кожу, желудочно-кишечный тракт, стенки желчных путей, слизистые оболочки, все биожидкости организма. Они производят витамины, оказывают помощь в переваривании еды, предотвращают чрезмерный рост вредных бактерий, регулируют иммунную систему, а также влияют на мозг. Для человека считается нормальной та микробиота, которая не вызывает болезни.
Следующий миф об опасности микробов. Кишечная палочка Escherichia coli была открыта немецким врачом и бактериологом Теодором Эшерихом в 1885 году. В настоящее время этот организм, находящийся в кишечнике, достаточно изучен. Подавление этих бактерий нарушает пищеварение. Но раньше кишечная палочка считалась смертельно опасным патогеном.
Биолог Илья Мечников в начале XX века первым предположил, что в кишечнике могут находиться микробы, необходимые для жизни. К этому заявлению его натолкнуло открытие бифидобактерий в 1899 году. Мечников поднял идею о ведущей роли микроорганизмов. Ученый призывал постоянно употреблять кисломолочные продукты, содержащие лактобактерии, – он считал их главным средством борьбы со старением и "самоотравлением" организма.
Только плохими или хорошими бактерии не могут быть, так как все зависит от их местоположения и условий. Бактерия Escherichia coli в кишечнике полезна, но за его пределами она вызывает воспаление органов и тканей. Попасть бактерия может через грязную воду, немытые руки или необработанную термически пищу. Главными источниками заражения считаются фекалии людей и животных, а также сточные воды.
Также ученые привели пример бактерии клостридии Clostridioides difficile, которая присутствует в микробиоме человека на протяжении всей жизни и обычно никак не проявляется. Однако при ослаблении иммунитета, в пожилом возрасте или при лечении антибиотиками бактерии способны вызвать тяжелое инфекционное заболевание прямой кишки.
Во время некоторых заболеваний состав микробиоты изменяется, обычно это называют дисбактериозом, что некорректно.
"Такие изменения редко бывают постоянными. Микробиота сильно различается как в здоровом состоянии, так и при заболевании. Это чрезвычайно затрудняет определение профиля нормальной кишечной микробиоты для клинической практики", – сообщили британские микробиологи в обзоре в Nature Microbiology.
Также эксперты развеяли миф о десятикратном превосходстве клеток микробиоты над самим организмом. На протяжении многих лет считалось, что в микробиоме взрослого человека порядка 100 триллионов бактериальных клеток при десяти триллионах собственных. Эти показатели были оценены в 2014 году в рамках проекта "Микробиом человека". Выяснилось, что тут примерно паритет.
В статье в Nature Microbiology ученые заявили, что вряд ли в человеке находятся от одного до двух килограммов бактерий.
"Большая часть человеческой микробиоты находится в толстой кишке. На микроорганизмы обычно приходится не более половины веса фекалий, а общее содержимое толстой кишки колеблется от 83 до 421 грамма. Средний человеческий стул во влажном состоянии весит около 200 граммов. В таком случае общий вес микробиоты точно не превышает 500 граммов, но, скорее всего, он значительно меньше", – рассчитали ученые.
Периодически можно встретить данные о том, что кишечная микрофлора передается по наследству. Специалисты выяснили, что только некоторые бактерии переходят от матери к ребенку. Ученые считают, что у каждого взрослого, даже если это однояйцевые близнецы, уникальный микробиом, по которому можно его идентифицировать.
Ученые проверили миф о влиянии бактерий на мозг. Считается, что между активностью бактерий в кишечнике и нейронов в мозге есть определенная связь. Изменения бактерий могут частично объяснять депрессию, ухудшение памяти, синдром хронической усталости, аутизм, шизофрению и нейродегенеративные расстройства. Однако не всегда понятно, являются изменения в микробиоме кишечника причиной или результатом заболевания.
Эксперты заявили, что кишечник обладает собственной системой нейронов, которая, с одной стороны, интегрирована в общую нервную систему организма, а с другой – в определенных случаях может функционировать автономно.
Ранее врач-диетолог Елена Соломатина рассказала, что овсяный кисель считается самым полезным для кишечника. Эксперт пояснила, что крахмалистый сахар в этом киселе отчасти сбраживается и проходит процесс ферментации, то есть появляются полезные бактерии. Она подчеркнула, что полезные бактерии благотворно влияют на кишечник.
Соломатина добавила, что полезные бактерии помогают укрепить иммунную и нервную системы, состояние которых во многом зависит от правильной работы ЖКТ.
"Доктор 24": врачи рассказали о микробиоме








Собянин: Главархив Москвы отреставрировал печатное издание Общей минеи



























